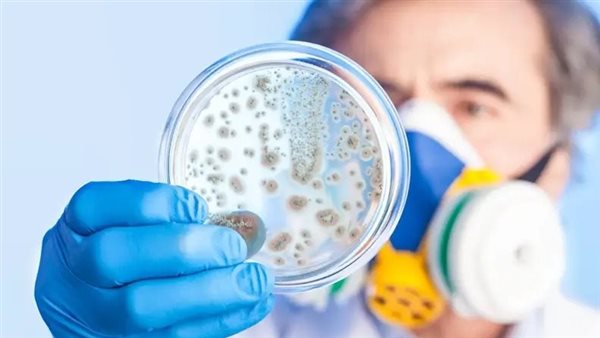
سلامة الغذاء

للوقاية من الأمراض.. علماء يطورون نظاما مبتكرا لتحديد بكتيريا الطعام
طور علماء نظامًا مبتكرًا وفعالًا لتحديد مسببات الأمراض على المنتجات الطازجة قبل توزيعها على منافذ البيع بالتجزئة والمطاعم، حيث تخضع المواد الغذائية الشائعة مثل، الخس والسبانخ بانتظام للاختبار بحثًا عن البكتيريا الضارة مثل السالمونيلا والليستريا المستوحدة وسلالات خطيرة من الإشريكية القولونية كوسيلة للوقاية من مرض المستهلك.
تطوير طرق اختبار سريعة للكشف عن أسباب أمراض الغذاء
وبحسب ما نشر بمجلة SciTech Daily، على الرغم من توفر طرق اختبار سريعة، إلا أنها لا تزال عملية تحتاج المزيد من الدقة للبحث عن أنواع البكتيريا قبل أن تنتقل إلى الإنسان عن طريق الغذاء.
ويريد باحثو جامعة ديلاوير اكتشاف هذه البكتيريا قبل أن يمرض أي شخص، والكشف عن مسببات الأمراض المنقولة بالغذاء في غضون ثلاث إلى ست ساعات.
وقال كالي كنييل أستاذ سلامة الأغذية الميكروبية، يمكن لشركات التكنولوجيا الحيوية أن تعزز سلامة الأغذية والصحة العامة، حيث أن هناك بعض العوامل الممرضة التي تجد طريقها بسهولة إلى النباتات، والتي يمكن أن تنتقل للإنسان بسهولة.
ووفقًا للباحثين، تستخدم النباتات آليات دفاع لمحاربة الأمراض، ولكن هناك بعض مسببات الأمراض التي تنتقل عن طريق المسام في الأوراق والجذع، نظرًا لأن هذه البكتيريا ليست مسببات أمراض حقيقية للنباتات، فلا يمكنك جسديًا رؤية العلامات المبكرة على تعرض النبات للإجهاد، وتتيح لنا تقنية الاستكشاف الحيوي أن نعلم ما إذا كان العامل الممرض موجودًا في النبات أم لا.






















